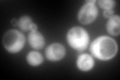
YJR105W

View description
Adenosine kinase, required for the utilization of S-adenosylmethionine (AdoMet); may be involved in recycling adenosine produced through the methyl cycle
Localization:
Intensity:
Fold change:
Significance:
-
C’ GFP library in SD
cytosol369.19 -
N' NOP1pr-GFP in SD

cytosol343.287 -
N' TEF2pr-mCherry in SD

missing0 -
N' NATIVEpr-GFP in SD

missing0 -
N' TEF2pr-VC and Cyto-VN in SD

#N/A0 -
C’ GFP library in SD+DTT

cytosol410.091.11No -
C’ GFP library in SD+H2O2

cytosol393.721.06No -
C’ GFP library in Starvation Media

nucleusN/AN/AYes -
C’ GFP library on the background of Pup2-DaMP

cytosol -
C’ GFP library on the background of CCT mutant

cytosol395.71.07179No
